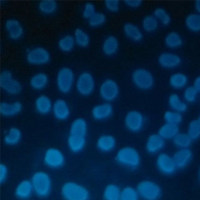
细胞Hochest凋亡染色实验服务

万千商家帮你免费找货
0 人在求购买到急需产品
- 详细信息
- 询价记录
- 文献和实验
- 技术资料
- 服务名称:
激光共聚焦显微镜检测服务
- 提供商:
晶莱生物
- 规格:
样本
激光共聚焦服务介绍:
激光共聚焦技术是利用激光束经照明针孔形成点光源对标本内焦平面的每一点扫描,照明针孔与探测针孔相对于物镜焦平面是共轭的,焦平面上的点同时聚焦于照明针孔和发射针孔,焦平面以外的点不会在探测针孔处成像,这样得到的共聚焦图像是标本的光学横断面。激光共聚焦扫描显微镜主要由激光光源系统、扫描检测系统、显微镜系统、计算机系统及相关软件等组成。
激光共聚焦显微镜设备应用范围:
1)对细胞、组织、活细胞进行连续扫描,获得精细的单个细胞或一群细胞的各个层面结构的图像;
2)能够对荧光标记或自发荧光微米或纳米球进行成像观察,可以观察载体内荧光标记药物的分布;
3)可以用于药物载体、药物对细胞的作用及其动力学研究,能够利用荧光标记,测定细胞内如钠、钙、镁、pH等离子浓度的比率及动态变化;
4)可以用于荧光标记或自发荧光微米或纳米药物载体的细胞吞噬行为及其在组织中的分布研究等。
晶莱生物病理类实验服务总览表
| 类别 | 服务项目 | 备注 | 说明 |
| 制 片 前 处 理 |
石蜡包埋 | 包埋1块 | 固定后组织按客户要求取材,脱水,包埋成蜡块(进口石蜡) |
| 特殊包埋(细胞、材料、眼球等) | 包埋1块 | 包埋要求难度较高(含特殊位置取材) | |
| 石蜡组织芯片 | 阵列点位包埋 | 客户提供供体蜡块及标本信息 | |
| 软化(肝硬化、皮肤结痂、植物等) | 1块标本软化 | 较为坚硬组织软化处理 | |
| 骨组织脱钙(小) | 1块标本脱钙 | 最大面≤2cm²骨组织脱钙 | |
| 骨组织脱钙(大) | 1块标本脱钙 | 最大面>2cm²骨组织脱钙 | |
| 骨组织EDTA脱钙(小) | 1块标本脱钙 | 最大面≤2cm²骨组织EDTA脱钙 | |
| 骨组织EDTA脱钙(大) | 1块标本脱钙 | 最大面>2cm²骨组织EDTA脱钙 | |
| 石蜡白片 | 石蜡白片1片 | 组织防脱载玻片石蜡白片 | |
| 冰冻组织制备 | 冰冻包埋及前处理 | 4%多.聚.甲.醛固定的组织或OCT包裹的新鲜组织(-80℃或液氮内保存,干冰运输) | |
| 冰冻切片 | 冰冻组织切片1片 | 同一组织连续切片3张以上免制备费 | |
| 染 色 |
HE染色 | 染色含切片 | 苏木.精-伊红染色法,观察组织形态 |
| 油红O染色 | 染色含冰冻切片 | 4%多.聚.甲.醛固定,冰冻切片。对组织内脂质(如脂滴)染色 | |
| 番红O固绿染色 | 染色含切片 | 常用于植物、软骨组织形态染色 | |
| Masson染色 | 染色含切片 | 观察组织纤维化和肌纤维的鉴别及组织纤维化程度 | |
| 天狼猩红染色 | 染色含切片 | 观察组织纤维化程度,及偏振光进行胶原亚型的分区 | |
| PAS糖原染色 | 染色含切片 | 观察肝脏、肌肉等组织内糖原的变化;肠胃肺支气管等杯状细胞酸性粘液物质变化 | |
| 阿利新蓝染色 | 染色含切片 | 常用于软骨组织或早幼粒细胞、巨核细胞染色 | |
| 甲苯.胺蓝染色 | 染色含切片 | 观察软骨组织形态或组织内肥大细胞的数量及分布 | |
| 尼氏染色 | 染色含切片 | 观察脑或脊髓等中枢神经系统内神经元尼氏体的变化 | |
| LFB髓鞘染色 | 染色含切片 | 观察神经髓鞘的形态及变化 | |
| 普鲁士蓝染色 | 染色含切片 | 常用于吞噬细胞内铁粒子的含量和定位 | |
| VG染色 | 染色含切片 | 显示组织胶原纤维及肌纤维的形态及变化 | |
| EVG染色 | 染色含切片 | 观察血管弹性纤维的形态及变化 | |
| VonKossa染色 | 染色含切片 | 观察组织内病理性钙沉积情况 | |
| 刚果红染色 | 染色含切片 | 一般用于组织淀粉样变染色 | |
| 维多利亚蓝染色 | 染色含切片 | 用于弹力纤维染色 | |
| 免疫 组化 |
免疫组化预式 | 染色含切片 | 试两个一抗浓度后拍照 |
| 免疫组化正式 | 染色含切片 | 客户提供一抗,常用二抗公司提供 | |
| 免疫组化芯片 | 染色含切片 | 免疫组化组织芯片染色 | |
| 免疫荧光(石蜡-单标) | 染色含切片和拍照 | 需实验前商定拍照倍数及视野 | |
| 免疫荧光(石蜡-双标) | 染色含切片和拍照 | 需实验前商定拍照倍数及视野 | |
| 免疫荧光(冰冻-单标) | 染色含冰冻切片和拍照 | 需实验前商定拍照倍数及视野 | |
| 免疫荧光(冰冻-双标) | 染色含冰冻切片和拍照 | 需实验前商定拍照倍数及视野 | |
| 抗体代购 | 详情请咨询工作人员 | ||
| Tunel | Tunel(POD自带试剂盒) | 染色含切片 | 细胞凋亡染色,客户需提供Tunel试剂盒 |
| Tunel(公司提供试剂盒) | 细胞凋亡染色,公司提供罗氏POD Tunel试剂盒 | ||
| 凋亡试剂盒代购 | 染色含切片 | 详情请咨询工作人员 |
晶莱病理实验室:长沙实验室;北京实验室;提前预约免费上门取样!
更多病理学实验服务内容详情请咨询晶莱生物!
晶莱生物服务流程
收费标准/服务周期/提供结果:
欢迎咨询详谈,我们会根据您的方案及需求制定详细的服务协议。
更多实验技术服务请浏览网站其他内容,或来电咨询!
做实验,找晶莱!您的科研生涯,我们一路相伴!
【平台项目开展范围】慢病毒,腺病毒,RNAi类,分子生物实验,病理实验,免疫学实验,细胞实验,动物实验,蛋白组学实验,芯片类实验,并为广大客户朋友们提供课题设计指导、基金申请指导等服务。
【北京公司】北京经济技术开发区科创十三街12号院德为科技园1号楼5层
【长沙公司】长沙市高新区麓谷大道627号新长海中心A1-1203室
【晶莱生物】已开展了数千个实验外包项目。我们专注于医学课题研究,已从课题申请、方案设计、试剂采购、模型构造、标本检测、数据分析,各个环节积累了数千个成功案例经验,为数千个来自临床的科研工作者解决了大量的科研问题。更多相关实验服务信息请咨询晶莱生物
风险提示:丁香通仅作为第三方平台,为商家信息发布提供平台空间。用户咨询产品时请注意保护个人信息及财产安全,合理判断,谨慎选购商品,商家和用户对交易行为负责。对于医疗器械类产品,请先查证核实企业经营资质和医疗器械产品注册证情况。
- 作者
- 内容
- 询问日期
文献和实验相关专题 最近需要做成骨细胞培养 的实验,师兄给个建议,说是可以做激光共聚焦显微镜检测。关于这个我还真不知道该如何下手设计这个实验,网上搜集了一些资料,分享给大家,供参考。 激光扫描共聚焦显微镜(laser scanning confocal microscope LSCM )是20世纪80年代发展起来的一项具有划时代意义的高科技新产品,是当今世界最先进的细胞生物学分析仪器。它是在荧光显微镜成象的基础上加装激光扫描装置
形态。4、到激光共聚焦观察室后,再将爬片取出,在干净的载玻片上滴一滴50%的甘油,然后将爬片取出来倒扣在滴过甘油的载玻片上(即细胞在2层玻片之间,一定不要反了哦;还有千万不要用中性树胶封片!5、显微镜下观察即可。
激光共聚焦扫描显微镜 LCSM照片,蓝色为细胞核,绿色为微管,图片来自http://www.itg.uiuc.edu 激光共聚焦扫描显微镜(laser confocal scanning microscope)用激光作扫描光源,逐点、逐行、逐面快速扫描成像,扫描的激光与荧光收集共用一个物镜,物镜的焦点即扫描激光的聚焦点,也是瞬时成像的物点。由于激光束的波长较短,光束很细,所以共焦激光扫描显微镜有较高的分辨力,大约是普通
技术资料暂无技术资料 索取技术资料